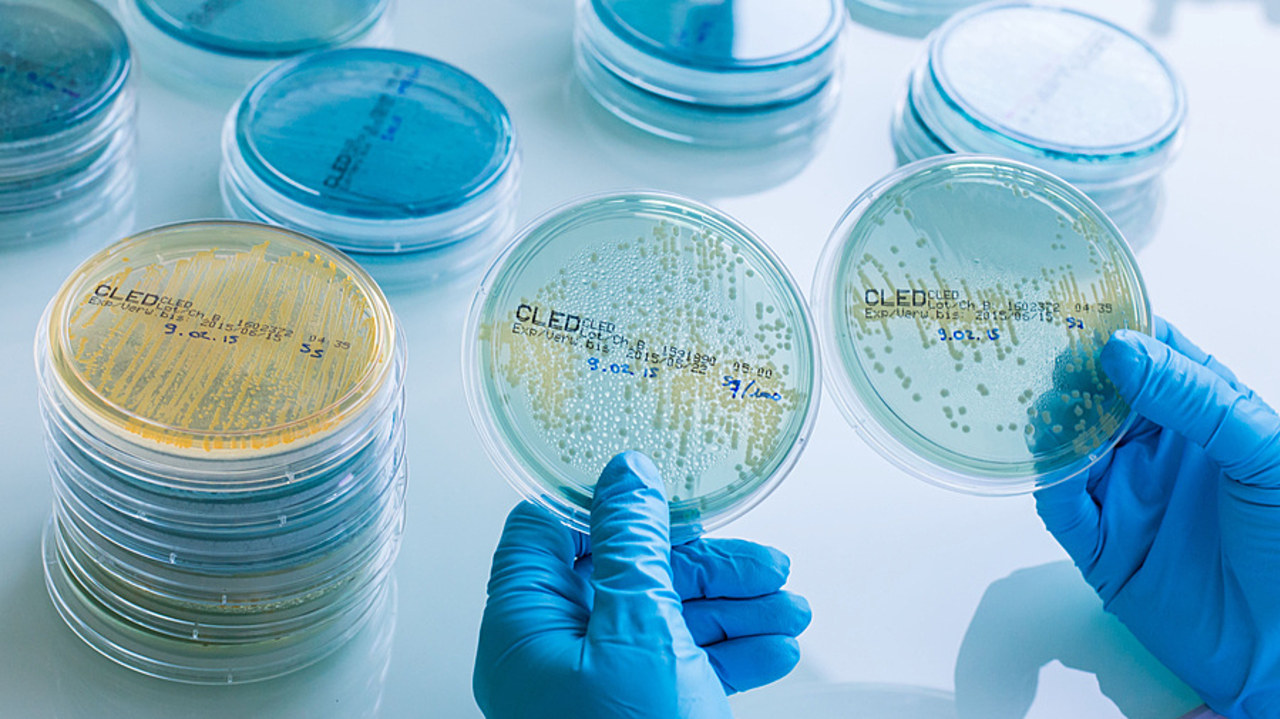
La surveillance de la montée de l'antibiorésistance passe aussi par les résultats d'antibiogrammes collectés dans le réseau de laboratoires Résapath. (Burger/Phanie)

18h06
Article
La mise en place d'une obligation vaccinale antigrippale reste l'objet d'interrogations
Par Jérôme Robillard
13 septembre 2024 à 12h21
À l'instar du cancer, la lutte contre la montée de résistance aux antimicrobiens dispose désormais d'un horizon à dix ans. La feuille de route interministérielle 2024…
La couverture complète des enjeux des territoires de santé, du sanitaire au médico-social.
Une édition synthétique envoyée chaque matin par email et un site mis à jour en temps réel.
Des contenus professionnalisants sur plus de 30 thématiques
Un accompagnement des managers et des gestionnaires dans leurs prises de décisions depuis plus de 20 ans.